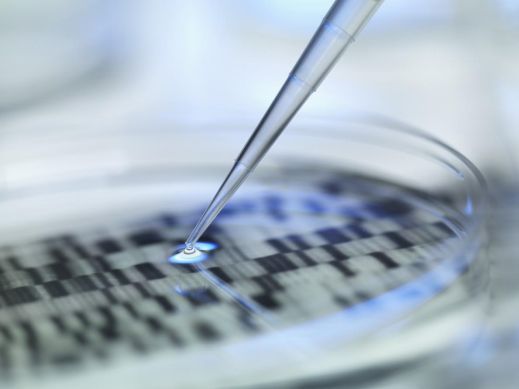

专注净水20年 沁园净界永无止境
二十年前,一本记叙水污染致病诉讼的著作《漫长的诉讼》在美国出版,书中污染者被惩治,但污染受害者受到的损伤却已无法挽回。多年来,类似的水污染事件在全球范围内不断爆发,水污染的严重程度已引起人类社会的重视,同时政府和社会力量的不断介入,以求将水污染带来的损失降至最低。

《漫长的诉讼》出版于1998年,正好是我国民用净水事业刚起步不久,也就在当年,沁园正式在宁波成立。在水污染遍地、人们净水需求旺盛、行业尚未规范的环境中,沁园一路带领中国净水不断走向成熟。时至今日,中国净水品牌技术实力已然超越外来品牌,为越来越多的用户提供饮水安全保护。
20年专注成就专业 沁园净界无止境
直到今天,消费者在电商平台搜索,依然能发现数百个净水品牌的存在,线下品牌更是难以计数。在多如牛毛的净水品牌中,产品质量可靠、售后服务完善的品牌却为数不多,能做到让消费者满意者更是凤毛麟角。专注净饮水20年,沁园凭借产品、技术、服务等多重优势跻身行业引领者行列。

奥维云网调研显示,在消费者认知中,净水品牌及产品的“专业性”是一个重要参照指标。扎根净水行业20年的沁园,始终将做好净水事业视为其唯一“使命”。可以说,这些年来专注于锤炼净水功夫,沁园早已将“专业”融入了品牌血脉,成为沁园的品牌标签之一。
沁园的专业,一方面体现在数量庞大的净水技术、创新成果上。多年来,沁园荣获百余项荣誉,包括“国家科学技术进步二等奖”、“中国专利优秀奖”、“中国标准创新贡献奖”等奖项;沁园坚持专业、专注和专心,同样坚持创新,获得家庭分质供水系统、净水机专用节水装置、智能水质检测装置等数百项国家专利技术;作为家用电器标准化技术委员会净水器及其系统化标准工作组组长单位,沁园曾牵头、参与起草《家用和类似用途饮用水处理装置》、《家用和类似用途饮用水处理内芯》等十余项国家以及行业标准。众多的技术、专利、标准,最终落地应用,成就了沁园出色的净水产品。

多年以来,沁园也一直在推动净水器的迭代升级,例如在滤芯自主研发、滤芯寿命提升、水效提升、净水流量、净水智能化以及其他诸多方面,沁园每年都在推出全新的成果,不断提升净水效果、丰富用户的使用体验。
洞察中国用户需求 用心呵护每个家庭
专注成就了沁园的技术与产品的专业性,同时也让沁园拥有良好的用户体验洞察力。为了了解国内消费者在净水器上的真实需求,沁园曾踏遍中国七大水系,建立了中国水质动态数据库。更值得一提的是,在今年上半年,沁园团队更是跋涉上万公里在全国范围内的水系取样调查。同时沁园还借助完善的CSM客户信息管理系统,收集大量用户需求信息,为产品的研发和设计提供了真实数据支持。
得益于沁园对中国消费者的深度洞察,沁园不断针对市场需求进行研发,不断为用户提供贴心的净水解决方案,引领净水器发展潮流,例如近期推出的集高精过滤、大流量、无桶鲜纯、高纯低废、智能人性等诸多特性于一身的新品,就很好地满足了消费者需求。
沁园的专注在服务上也展现得淋漓尽致。除了前述CSM客户管理系统,沁园还建立了规模超过100人的呼叫中心,客服团队365天全年无休为用户解决产品的咨询、安装、保养等问题,赢得了良好的用户口碑。此外,沁园还基于微信公众号平台建立了集售后、选购及会员服务于一体的服务受理平台,用户可以随时随地为自家沁园净水器预约售后服务。

沁园相关负责人表示,沁园是一家专注净水的品牌,多年来为用户饮水健康孜孜以求,满足了中国消费者的净水需求。对沁园来说,对净水的追求是没有止境的,未来为20%中国家庭提供净水保障是沁园的品牌愿景。为了实现这一目标,沁园将一如既往地坚持创新、不断提升净水产品与服务品质。
网址:专注净水20年 沁园净界永无止境 https://www.jiaju82.com/news-view-id-626771.html
